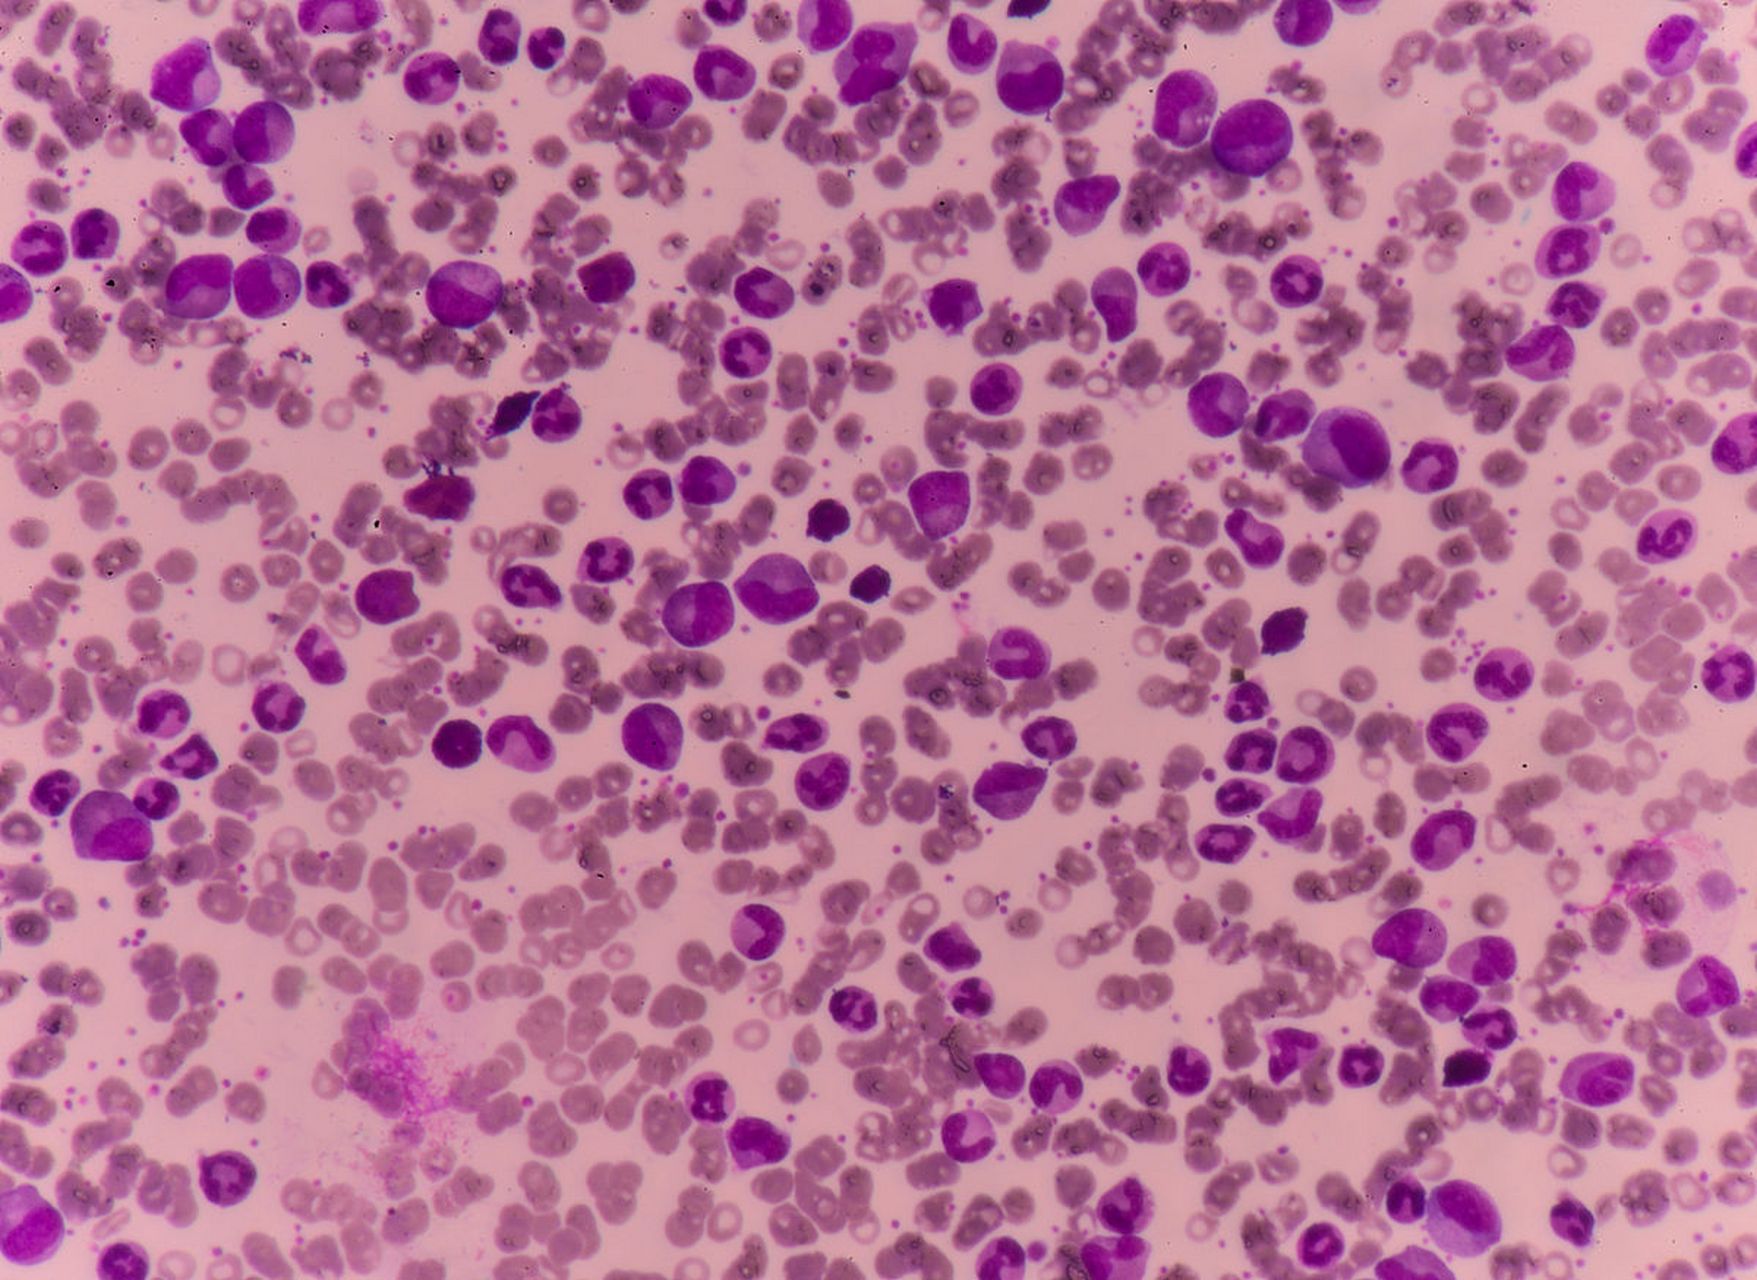
有些人认为,肺炎支原体感染存在季节性高峰,每隔3-5年就会迎来一次

肺支原体

支原体肺炎:双肺感染.#快点好起来 #医院97 #熬过了就好 - 抖音
图片尺寸1440x3200
肺支原体肺炎
图片尺寸420x421
支原体肺发科普_林氏_状况_用药
图片尺寸1200x1756
中医科普——支原体肺炎 秋冬呼吸道疾病高发 图解支原体肺 - 抖音
图片尺寸750x1123
一图读懂什么是支原体肺炎华为手表可初筛肺感染风险
图片尺寸1080x1709
肺炎支原体,新冠,流感叠加感染?
图片尺寸700x615
肺炎支原体阳性是什么意思 肺炎支原体阳性,这一检查结果往往让许多
图片尺寸960x1280
涨知识科普# 儿童肺炎支原体肺炎是一种常见的呼吸道感染,在选择合理
图片尺寸2530x1280
肺炎支原体肺炎再认识
图片尺寸1080x608
肺炎支原体肺炎
图片尺寸690x1494
肺炎支原体肺炎再认识
图片尺寸1080x608
又是支原体肺炎
图片尺寸2448x2448
肺炎支原体感染11月或将迎感染高峰#育儿图文来了 #支原体肺 - 抖音
图片尺寸1080x1336
什么是支原体肺炎
图片尺寸830x414
肺支原体感染的治疗之路
图片尺寸1242x1660
有些人认为,肺炎支原体感染存在季节性高峰,每隔3-5年就会迎来一次
图片尺寸1757x1280
感染肺炎支原体后,如何科学应对?
图片尺寸1080x855
肺支原体肺炎
图片尺寸600x800
医生不建议自测肺炎支原体:支原体肺炎自测盒准确率低,结果不能作为
图片尺寸480x853
支原体肺炎吗?
图片尺寸654x1236